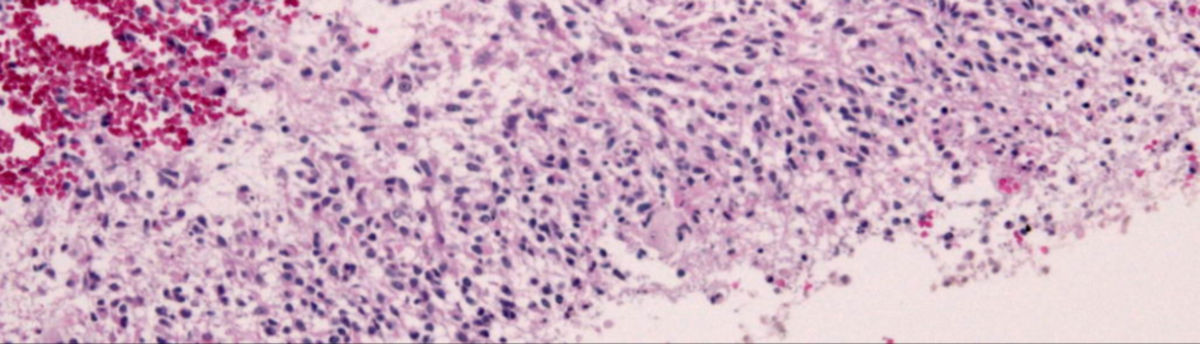
Glioblastom Fortschritt durch neue Therapie DocCheck

Das epitheloide Glioblastom ist eine Variante des Glioblastomes. Zusammen mit dem Gliosarkom und dem Riesenzellglioblastom wird es als IDH-Wildtyp bezeichnet und in der WHO-Klassifikation der Tumoren des zentralen Nervensystems als Grad IV eingestuft.
Ob epitheloide Glioblastome von rhabdoiden Glioblastomen unterschieden sind, ist derzeit nicht klar, letzter Begriff wird jedoch in der aktuellen WHO-Klassifikation nicht verwendet.
Bei dieser Form finden sich große Epitheloidzellen mit reichlich eosinophilem Zytoplasma, sie erinnern an Melanomzellen. Manchmal sind auch Rhabdoidzellen dabei. In etwa 50 % lassen sich BRAF V600E Mutationen nachweisen.
Verbreitung
Diese Form findet sich häufiger bei jungen Erwachsenen und Kindern. Mitunter tritt sie zusammen mit dem pleomorphen Xanthoastrozytom vergesellschaftet auf.
Klinische Erscheinungen
Die Aussichten gelten wegen des aggressiven Wachstums als schlechter gegenüber dem „normalen“ Glioblastom. Manchmal kommt es zu Fernmetastasen.
Klinische Erscheinungen, Diagnostik und Therapie entsprechen ansonsten dem Glioblastom, siehe dort.
Differentialdiagnose
Abzugrenzen ist bei Kindern ein Atypischer teratoider/rhabdoider Tumor.
Literatur
- KM. C. Burger, M. W. Ronellenfitsch, N. I. Lorenz, M. Wagner, M. Voss, D. Capper, T. Tzaridis, U. Herrlinger, J. P. Steinbach, G. Stoffels, K. J. Langen, C. Brandts, C. Senft, P. N. Harter, O. Bähr: Dabrafenib in patients with recurrent, BRAF V600E mutated malignant glioma and leptomeningeal disease. In: Oncology Reports. Band 38, Nummer 6, Dezember 2017, S. 3291–3296, doi:10.3892/or.2017.6013, PMID 29039591, PMC 5783574 (freier Volltext).
Einzelnachweise
Weblinks
- Pathology Outlines
- Hirntumorhilfe